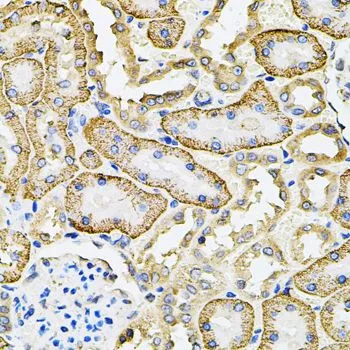

WB analysis of LNCaP cell lysate using GTX54676 SLC4A4 antibody. Dilution : 1:1000 Loading : 25microg per lane
SLC4A4 antibody
GTX54676
ApplicationsImmunoFluorescence, Western Blot, ImmunoCytoChemistry, ImmunoHistoChemistry, ImmunoHistoChemistry Paraffin
Product group Antibodies
TargetSLC4A4
Overview
- SupplierGeneTex
- Product NameSLC4A4 antibody
- Delivery Days Customer7
- Application Supplier NoteWB: 1:500 - 1:2000. ICC/IF: 1:50 - 1:200. IHC-P: 1:50 - 1:200. *Optimal dilutions/concentrations should be determined by the researcher.Not tested in other applications.
- ApplicationsImmunoFluorescence, Western Blot, ImmunoCytoChemistry, ImmunoHistoChemistry, ImmunoHistoChemistry Paraffin
- CertificationResearch Use Only
- ClonalityPolyclonal
- ConjugateUnconjugated
- Gene ID8671
- Target nameSLC4A4
- Target descriptionsolute carrier family 4 member 4
- Target synonymsHNBC1, KNBC, NBC1, NBC2, NBCe1, NBCe1-A, PRTAO, SLC4A5, hhNMC, kNBC1, pNBC, electrogenic sodium bicarbonate cotransporter 1, Na(+)/HCO3(-) cotransporter, kidney type Na+/HCO3- cotransporter, pancreatic sodium bicarbonate cotransporter, sodium bicarbonate cotransporter 1 (sodium bicarbonate cotransporter, kidney; sodium bicarbonate cotransporter, pancreas), solute carrier family 4 (sodium bicarbonate cotransporter), member 4, solute carrier family 4, sodium bicarbonate cotransporter, member 4, brain type, solute carrier family 4, sodium bicarbonate cotransporter, member 5
- HostRabbit
- IsotypeIgG
- Protein IDQ9Y6R1
- Protein NameElectrogenic sodium bicarbonate cotransporter 1
- Scientific DescriptionThis gene encodes a sodium bicarbonate cotransporter (NBC) involved in the regulation of bicarbonate secretion and absorption and intracellular pH. Mutations in this gene are associated with proximal renal tubular acidosis. Multiple transcript variants encoding different isoforms have been found for this gene. [provided by RefSeq, Oct 2008]
- Storage Instruction-20°C or -80°C,2°C to 8°C
- UNSPSC12352203